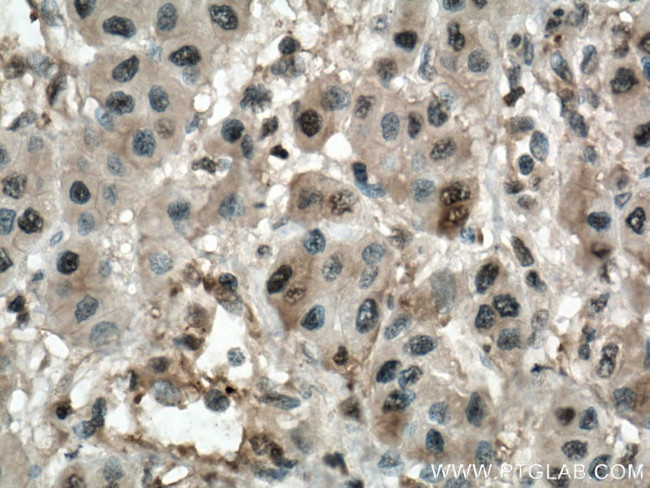
PSMB8 Antibody in Immunohistochemistry (Paraffin) (IHC (P))

Search
Proteintech
PSMB8 Monoclonal Antibody (2A5B6)
{{$productOrderCtrl.translations['antibody.pdp.commerceCard.promotion.promotions']}}
{{$productOrderCtrl.translations['antibody.pdp.commerceCard.promotion.viewpromo']}}
{{$productOrderCtrl.translations['antibody.pdp.commerceCard.promotion.promocode']}}: {{promo.promoCode}} {{promo.promoTitle}} {{promo.promoDescription}}. {{$productOrderCtrl.translations['antibody.pdp.commerceCard.promotion.learnmore']}}
产品信息
66759-1-IG
种属反应
宿主/亚型
分类
类型
克隆号
抗原
偶联物
形式
浓度
规格
纯化类型
保存液
内含物
保存条件
运输条件
产品详细信息
Immunogen sequence: MLIGTPTPR DTTPSSWLTS SLLVEAAPLD DTTLPTPVSS GCPGLEPTEF FQSLGGDGER NVQIEMAHGT TTLAFKFQHG VIAAVDSRAS AGSYISALRV NKVIEINPYL LGTMSGCAAD CQYWERLLAK ECRLYYLRNG ERISVSAASK LLSNMMCQYR GMGLSMGSMI CGWDKKGPGL YYVDEHGTRL SGNMFSTGSG NTYAYGVMDS GYRPNLSPEE AYDLGRRAIA YATHRDSYSG GVVNMYHMKE DGWVKVESTD VSDLLHQYRE ANQ (1-272 aa encoded by BC001114)
靶标信息
The proteasome is a multicatalytic proteinase complex with a highly ordered ring-shaped 20S core structure. The core structure is composed of 4 rings of 28 non-identical subunits; 2 rings are composed of 7 alpha subunits and 2 rings are composed of 7 beta subunits. Proteasomes are distributed throughout eukaryotic cells at a high concentration and cleave peptides in an ATP/ubiquitin-dependent process in a non-lysosomal pathway. An essential function of a modified proteasome, the immunoproteasome, is the processing of class I MHC peptides. This gene encodes a member of the proteasome B-type family, also known as the T1B family, that is a 20S core beta subunit. This gene is located in the class II region of the MHC (major histocompatibility complex). Expression of this gene is induced by gamma interferon and this gene product replaces catalytic subunit 3 (proteasome beta 5 subunit) in the immunoproteasome. Proteolytic processing is required to generate a mature subunit. Two alternative transcripts encoding two isoforms have been identified; both isoforms are processed to yield the same mature subunit.
仅用于科研。不用于诊断过程。未经明确授权不得转售。
篇参考文献 (0)
生物信息学
蛋白别名: DAAP-57C1.3; Low molecular mass protein 7; low molecular weight protein 7; Macropain subunit C13; MGC1491; Multicatalytic endopeptidase complex subunit C13; OTTHUMP00000029420; OTTHUMP00000029421; OTTHUMP00000062981; protease component C13; proteasome (prosome, macropain) subunit, beta type, 8 (large multifunctional peptidase 7); proteasome catalytic subunit 3i; Proteasome component C13; proteasome subunit beta 5i; proteasome subunit beta 8; Proteasome subunit beta type-8; Proteasome subunit beta-5i; proteasome subunit Y2; proteasome-related gene 7; PSMB8; Really interesting new gene 10 protein; RING10; unnamed protein product
基因别名: ALDD; D6S216; D6S216E; JMP; LMP7; NKJO; PRAAS1; PSMB5i; PSMB8; RING10; Y2
UniProt ID: (Human) P28062
Entrez Gene ID: (Human) 5696